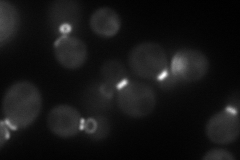
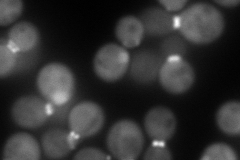
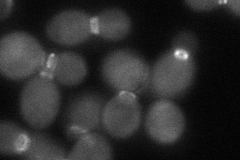
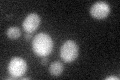

View description
Component of the septin ring of the mother-bud neck that is required for cytokinesis; septins recruit proteins to the neck and can act as a barrier to diffusion at the membrane, and they comprise the 10nm filaments seen with EM
Localization:
Intensity:
Fold change:
Significance:
-
C’ GFP library in SD

below threshold15.22 -
N' NOP1pr-GFP in SD
bud neck116.29 -
N' TEF2pr-mCherry in SD
bud neck205.246 -
N' NATIVEpr-GFP in SD

bud neck43.1099 -
N' TEF2pr-VC and Cyto-VN in SD
bud neck61.0312 -
C’ GFP library in SD+DTT
cytosol17.221.13No -
C’ GFP library in SD+H2O2

cytosol16.551.08No -
C’ GFP library in Starvation Media

cytosol15.641.02No -
C’ GFP library on the background of Pup2-DaMP

below threshold -
C’ GFP library on the background of CCT mutant

below threshold16.91321.11045No
